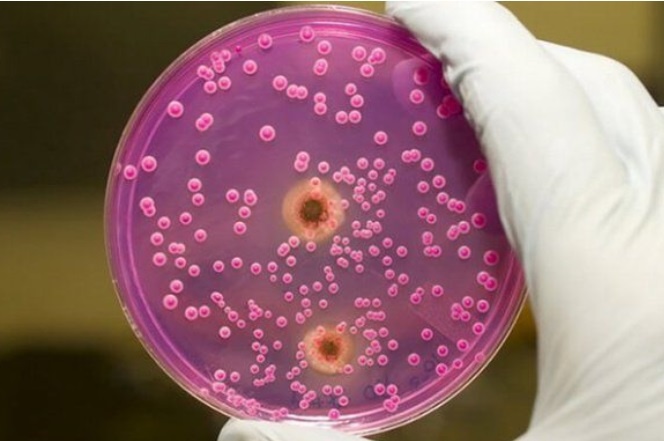

|
|
Viêm ruột thừa do vi khuẩn lao là tình huống hiếm gặp. Ảnh: BVCC. |
Người đàn ông 57 tuổi (trú tại Chí Linh, Hải Dương) được đưa đến Bệnh viện Việt Nam - Thụy Điển Uông Bí (Quảng Ninh) trong tình trạng đau bụng dữ dội. Qua thăm khám, các bác sĩ chẩn đoán người bệnh bị viêm ruột thừa và tiến hành phẫu thuật cắt bỏ. Mẫu bệnh phẩm sau đó được gửi đến khoa Giải phẫu bệnh để làm xét nghiệm mô bệnh học.
Kết quả xét nghiệm cho thấy ông bị viêm ruột thừa do vi khuẩn lao – một tình trạng hiếm gặp với tỷ lệ chỉ 1,5-3% ở người mắc lao. Sau phẫu thuật, bệnh nhân hồi phục tốt, được xuất viện và tiếp tục điều trị lao theo phác đồ.
Bác sĩ Trương Thị Thảo Hương, khoa X-quang chẩn đoán, Bệnh viện Trung ương Quân đội 108, cho biết tuột thừa là một cấu trúc của ống tiêu hóa ở đáy manh tràng, gần chỗ tiếp nối giữa ruột non và đại tràng bên phải.
Thông thường, ruột thừa nằm ở hố chậu phải. Ngoài ra còn có thể gặp ruột thừa ở một số vị trí khác như giữa ổ bụng, vùng dưới gan phải, giữa các quai ruột non hoặc hiếm hơn là nằm ở hố chậu trái.
Thông thường, ruột thừa dài khoảng 5-35 cm và có đường kính nhỏ hơn 6 mm. Tuy nhiên, trong một số trường hợp, ruột thừa có thể phát triển to hơn, được gọi là viêm ruột thừa kích thước lớn.
Viêm ruột thừa cấp tính, bao gồm cả trường hợp kích thước lớn, thường do sự tắc nghẽn trong lòng ruột thừa dẫn đến viêm nhiễm. Các nguyên nhân phổ biến gây tắc nghẽn bao gồm: Sỏi phân, ký sinh trùng (giun đũa chui vào ruột thừa), dị vật thức ăn (hạt, quả)... Trong đó, viêm ruột thừa do lao là nguyên nhân tương đối hiếm gặp.
Theo bác sĩ chuyên khoa Phạm Thị Hoa, khoa Giải phẫu bệnh, Bệnh viện Việt Nam - Thụy Điển Uông Bí, phát hiện sớm viêm ruột thừa do lao có ý nghĩa quan trọng, giúp bác sĩ điều chỉnh phác đồ điều trị phù hợp, ngăn ngừa biến chứng nguy hiểm.
Tuy nhiên, bệnh lý này rất khó chẩn đoán do biểu hiện lâm sàng tương tự viêm ruột thừa thông thường, thậm chí không có triệu chứng gợi ý. Các phương pháp siêu âm hay chụp cắt lớp ổ bụng cũng không đặc hiệu.
Chẩn đoán xác định chỉ có thể thực hiện thông qua xét nghiệm mô bệnh học. Trong một số trường hợp, kết quả xét nghiệm có thể bị nhầm lẫn với tổn thương viêm hạt hoặc bệnh sarcoidosis.
Do đó, người bệnh cần được thăm khám tại cơ sở y tế có chuyên môn để phát hiện chính xác nguyên nhân viêm ruột thừa, tránh bỏ sót các tổn thương nguy hiểm, đặc biệt là tổn thương ác tính.
Học cách già đi
Bước vào tuổi xế chiều, nhiều người cảm thấy hụt hẫng. Họ không còn công việc để làm, mất đi sự năng động vốn có và trở nên tự ti. Về già, hãy học cách yêu cuộc đời một lần nữa.
Trong cuốn sách Khoa học tâm thức, Carl Jung mổ xẻ một số lĩnh vực quan trọng và gây tranh cãi nhất trong tâm lý học phân tích: Phân tích giấc mơ, vô thức nguyên thủy và mối quan hệ giữa tâm lý học và tôn giáo. Ông cũng xem xét những khác biệt giữa lý thuyết của mình và của Freud, cung cấp kiến thức về các nguyên tắc cơ bản của phân tâm học.